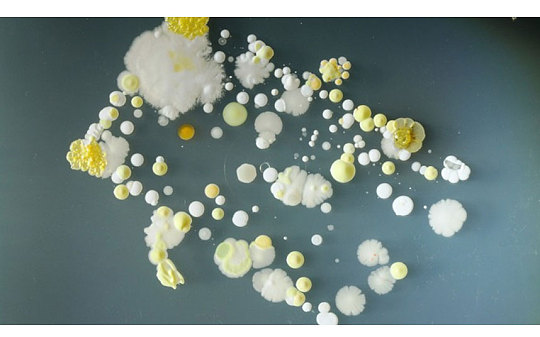
Batteri
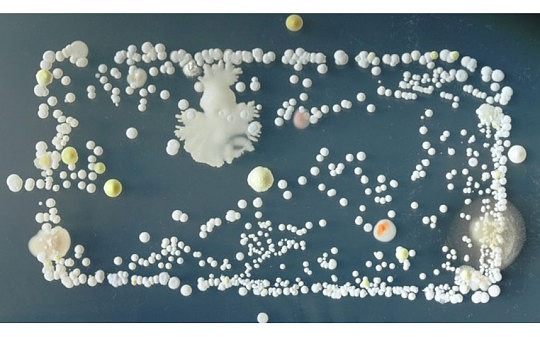
Batteri
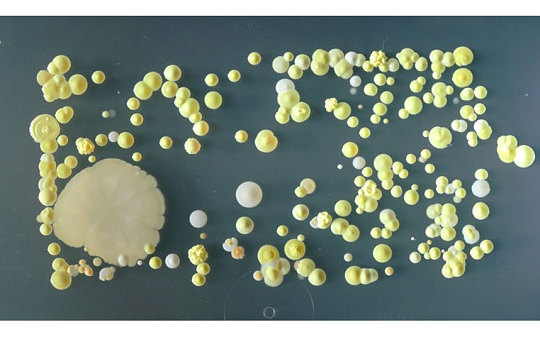
Batteri

Gli studenti di biologia dell’Università del Surrey (Regno Unito), hanno inserito i loro telefoni in una piastra di Petri, un recipiente piatto di vetro o plastica, esaminando la crescita di colture cellulari batteriche con il passare del tempo. Dopo tre giorni i batteri hanno cominciato a crescere di numero: benché la maggior parte presenti un aspetto piuttosto disgustoso (almeno agli occhi di noi profani) pare siano innocui. In alcune formazioni in particolare sono state notate tracce di staphylococcus aureus, un batterio normalmente presente a livello della cute, della mucosa della porzione anteriore del naso e in grado di causare varie infezioni sotto forma di piccole bolle, ascessi alla pelle e infezioni.
Ogni anno il Dr Simon Parks chiede ai propri studenti di immergere i telefoni nel diffuso strumento per la coltura in precedenza sterilizzato, come parte del suo corso di batteriologia biomedica all’Università. “I telefoni portatili non ricordano solo i numeri di telefono ma ospitano anche la storia dei nostri contatti fisici come quelli avvenuti con le altre persone, con il suolo e altre sostanze” ha dichiarato Parks. “È insolito ma è un modo molto efficace di coinvolgere gli studenti con la microbiologia, spesso trascurata nella vita di tutti i giorni”. Il Dr Parks suggerisce di pulire i telefoni una volta a settimana con un disinfettante evitando in questo modo di favorire la crescita di alcuni dei batteri visibili in queste foto. Anche lavare spesso le mani, riduce al minimo la crescita di possibili batteri.

![iGuide per i regali di Natale - macitynet..ti CTA Natale iGuida [per Settimio] - macitynet.it](https://www.macitynet.it/wp-content/uploads/2025/12/regali-di-natale-consigli-di-macitynet.jpg)











